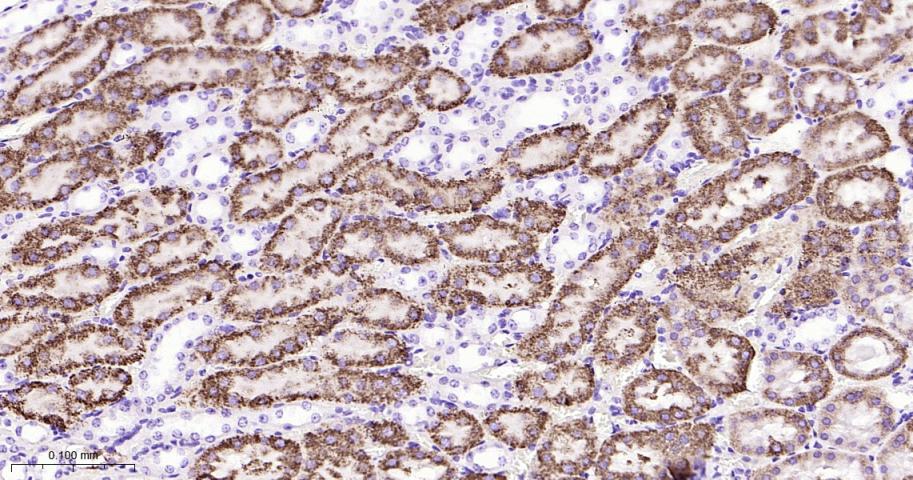
P-糖蛋白重组兔单克隆抗体

P Glycoprotein Recombinant Rabbit mAb (一抗) - WB,IHC-P,IHC-F,IF | Bioss
Rrmab?兔单抗

货号:bsm-54782R
产品详情
相关标记
相关产品
相关文献
常见问题
概述
产品编号
bsm-54782R
产品类型
重组兔单抗、离子通道抗体、mIHC精品抗体
英文名称
P Glycoprotein Recombinant Rabbit mAb
中文名称
P-糖蛋白重组兔单克隆抗体
英文别名
ABC20; CD243; CLCS; ENPAT; GP170; MDR1; P-GP; PGY1; p-170; Abcb1; Mdr1b; Pgy-1; mdr; MDR1_HUMAN; ATP-binding cassette sub-family B member 1; Multidrug resistance protein 1; P-glycoprotein 1; Phospholipid transporter ABCB1; MDR1B_MOUSE; Abcb1b; ATP-binding cassette sub-family B member 1B; Multidrug resistance protein 1B; Pgy1-1;
抗体来源
Rabbit
免疫原
Recombinant Human P-glycoprotein 1 protein
亚型
IgG
性状
Liquid
纯化方法
affinity purified by Protein A
克隆类型
Recombinant
克隆号
2C11
理论分子量
141 kDa
检测分子量
140-180 kDa
浓度
1mg/ml
储存液
1*TBS (pH7.4), 0.05% BSA, 40% Glycerol. Preservative: 0.02% Proclin300.
研究领域
SWISS
Gene ID
保存条件
Shipped at 4℃. Store at -20℃ for one year. Avoid repeated freeze/thaw cycles.
注意事项
This product as supplied is intended for research use only, not for use in human, therapeutic or diagnostic applications.
数据库链接
产品介绍
信号传导(Signaling Intermediates)
背景资料
bs-1468P is one synthetic peptide derived from human MDR1.
P Glycoprotein, the product of the MDR1 gene, is expressed in distinct non-malignant cells, typically cells with secretory and excretory functions. It is assumed to function as an ATP-dependent drug efflux pump with broad substrate specificity. The highest expression of P Glycoprotein has been observed in kidney (proximal tubules), liver (bile canaliculi), adrenal gland and intestine, suggesting that the primary role of P Glycoprotein is in the normal secretion of physiological metabolites and ingested chemicals into bile, urine and the lumen of the intestinal tract. Elevated levels of P Glycoprotein have also been reported in multidrug-resistant cell lines and in colon, endometrial, ovarian, and breast tumors, as well as in sarcomas and leukemias / lymphomas.
P Glycoprotein, the product of the MDR1 gene, is expressed in distinct non-malignant cells, typically cells with secretory and excretory functions. It is assumed to function as an ATP-dependent drug efflux pump with broad substrate specificity. The highest expression of P Glycoprotein has been observed in kidney (proximal tubules), liver (bile canaliculi), adrenal gland and intestine, suggesting that the primary role of P Glycoprotein is in the normal secretion of physiological metabolites and ingested chemicals into bile, urine and the lumen of the intestinal tract. Elevated levels of P Glycoprotein have also been reported in multidrug-resistant cell lines and in colon, endometrial, ovarian, and breast tumors, as well as in sarcomas and leukemias / lymphomas.

产品应用
| 应用 | 已检合格种属 | 预测种属 | 推荐稀释比例 |
|---|---|---|---|
| WB | Human, Mouse, Rat | 1:500-2000 | |
| IHC-P | Human, Mouse, Rat | 1:100-500 | |
| IHC-F | Human, Mouse, Rat | 1:100-500 | |
| IF | Human, Mouse, Rat | 1:100-500 |
交叉反应
交叉反应: Human, Mouse, Rat
相关产品
暂无相关产品
靶标
基因名
ABCB1
蛋白名
ATP-dependent translocase ABCB1
亚基
Interacts with PSMB5.
亚细胞定位
Cell membrane; Multi-pass membrane protein.
组织特异性
Expressed in liver, kidney, small intestine and brain.
疾病
Genetic variations in ABCB1 are associated with susceptibility to inflammatory bowel disease type 13 (IBD13) [MIM:612244]. Inflammatory bowel disease is characterized by a chronic relapsing intestinal inflammation. It is subdivided into Crohn disease and ulcerative colitis phenotypes. Crohn disease may involve any part of the gastrointestinal tract, but most frequently the terminal ileum and colon. Bowel inflammation is transmural and discontinuous; it may contain granulomas or be associated with intestinal or perianal fistulas. In contrast, in ulcerative colitis, the inflammation is continuous and limited to rectal and colonic mucosal layers; fistulas and granulomas are not observed. Both diseases include extraintestinal inflammation of the skin, eyes, or joints. Crohn disease and ulcerative colitis are commonly classified as autoimmune diseases.
相似性
Belongs to the ABC transporter superfamily. ABCB family. Multidrug resistance exporter (TC 3.A.1.201) subfamily.
Contains 2 ABC transmembrane type-1 domains.
Contains 2 ABC transporter domains.
Contains 2 ABC transmembrane type-1 domains.
Contains 2 ABC transporter domains.
功能
Energy-dependent efflux pump responsible for decreased drug accumulation in multidrug-resistant cells.
Subunit : Interacts with PSMB5.
同靶标产品
相关文献
提示: 发表研究结果有使用 bsm-54782R 时请让我们知道,以便我们可以引用参考文章。作为回馈,资料提供者将获得我们送上的小礼品。